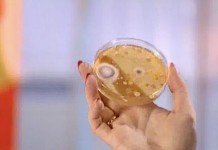

Архив
Масляный компресс
Масляный компресс хорош для маленьких детей, у которых бронхит или пневмония. О том, как правильно его сделать, расскажет фотохудожник Екатерина
Противопростудные растения
Какие комнатные растения убивают вирусы и микробы и способствуют не только профилактике простудных заболеваний, но и скорейшему выздоровлению.
29 ноября 2003
• В Турции живет кошка, которой врачи, после того как она попала под машину, создали специальную конструкцию, позволяющую животному передвигаться • Пчелиные укусы избавят от многих болезней.
Плохие и хорошие микробы
Что такое микробы, какие из них хорошие, а какие плохие, как защититься от плохих микробов.
История Маши Черношенцевой
У Маши Черношенцевой ДЦП. У девочки настолько сильно спазмированы мышцы, что без помощи взрослых она не может ни стоять, ни ходить. Врачи назначили Маше новый лекарственный препарат для снятия мышечных спазмов.
Программа "Здоровье" от 29 ноября 2003 г.
• Противопростудные комнатные растения • Возвращение из страны глухих: как научить ребенка слышать и говорить • Народные советы: масляный компресс • Правда жизни: история Маши Черношенцевой • Детская рубрика: плохие и хорошие микробы.
22 ноября 2003
• В Швейцарии стартовала необычная акция по борьбе с курением • В Медицинском радиологическом научном центре
Маска для волос от Арины Шараповой
Ваши волосы сухие и тусклые? Сделать их здоровыми и блестящими поможет маска для волос от телеведущей Арины Шараповой.
Зачем человеку нос?
Что такое нос, зачем он нужен человеку.
Программа "Здоровье" от 22 ноября 2003 г.
• Худеют все: презентация проекта • Пародонтит: лечение • Народные советы: маска для волос • Плазменный скальпель • Детская рубрика: зачем человеку нос?
Маска для рук от Арины Шараповой
Эта маска состоит из кофейной гущи и жирной сметаны и делает кожу рук белой и очень мягкой.
15 ноября 2003
• Открытие в области лечения женского бесплодия • Как влияют веселые посиделки и кружка пива на мужской и женский ум • Чтение "Гарри Поттера" опасно для детей • Правильное лечение гипертонической болезни может уменьшить смертность на 50%.
Орган равновесия
Где расположен орган равновесия, можно ли его натренировать.
Новый метод лечения трофических язв
В Институте хирургии им. А. В. Вишневского разработан уникальный метод лечения трофических язв с помощью стерильного воздуха.
История Ирины Васильевны Кашириной
Несколько лет Ирину Васильевну Каширину мучили невыносимые боли в сердце, причина которых – атеросклеротическая бляшка, закрывшая просвет сосуда.
Программа "Здоровье" от 15 ноября 2003 г.
• Правда жизни: история Кашириной И. В. • Пародонтит: особенности чистки зубов • Народные советы: маска для рук • Новый метод лечения трофических язв • Детская рубрика: орган равновесия.
Программа "Здоровье" от 8 ноября 2003 г.
• Прорыв в медицине: трехмерное УЗИ • Народные советы: салат "
8 ноября 2003
• Здорово ли ваше сердце? Диагноз поставит нижнее белье • Правительство Франции объявило настоящую войну курильщикам • Ученые из США предложили новый подход к лечению насморка.
Температура тела
Какая температура тела считается нормальной, почему она повышается.
Новый метод лечения абсолютной глухоты
Маленький компьютер, вмонтированный в мозг, дает ребенку возможность слышать и говорить. История Артура Кислова – глухого от рождения мальчика, которому год назад была проведена уникальная операция.